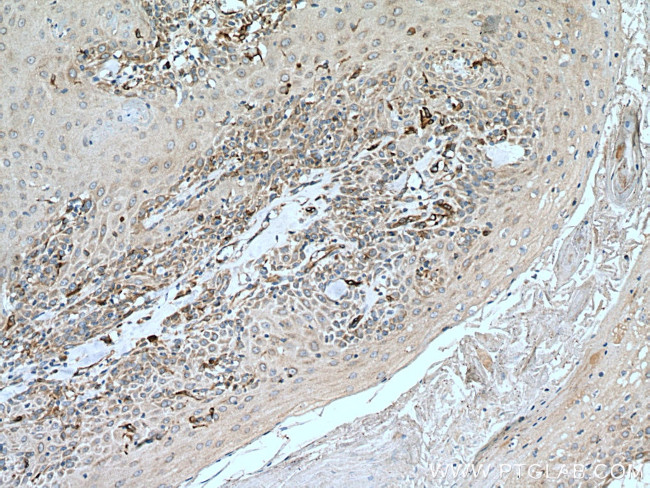
SLC27A3 Antibody in Immunohistochemistry (Paraffin) (IHC (P))

Search
Proteintech
SLC27A3 Polyclonal Antibody
{{$productOrderCtrl.translations['antibody.pdp.commerceCard.promotion.promotions']}}
{{$productOrderCtrl.translations['antibody.pdp.commerceCard.promotion.viewpromo']}}
{{$productOrderCtrl.translations['antibody.pdp.commerceCard.promotion.promocode']}}: {{promo.promoCode}} {{promo.promoTitle}} {{promo.promoDescription}}. {{$productOrderCtrl.translations['antibody.pdp.commerceCard.promotion.learnmore']}}
产品信息
12943-1-AP
种属反应
已发表种属
宿主/亚型
分类
类型
抗原
偶联物
形式
浓度
规格
纯化类型
保存液
内含物
保存条件
运输条件
产品详细信息
Immunogen sequence: GEPGLLVAP VSQQSPFLGY AGGPELAQGK LLKDVFRPGD VFFNTGDLLV CDDQGFLRFH DRTGDTFRWK GENVATTEVA EVFEALDFLQ EVNVYGVTVP GHEGRAGMAA LVLRPPHALD LMQLYTHVSE NLPPYARPRF LRLQESLATT ETFKQQKVRM ANEGFDPSTL SDPLYVLDQA VGAYLPLTTA RYSALLAGNL RI (500-700 aa encoded by BC029792)
靶标信息
SLC27A3 has acyl-CoA ligase activity for long-chain and very-long-chain fatty acids.SLC27A3 does not exhibit fatty acid transport activity.
仅用于科研。不用于诊断过程。未经明确授权不得转售。
生物信息学
蛋白别名: Arachidonate--CoA ligase; FATP-3; fatty acid transport protein 3; Long-chain fatty acid transport protein 3; Long-chain-fatty-acid--CoA ligase; mFLJ00207 protein; solute carrier family 27 (fatty acid transporter), member 3; Solute carrier family 27 member 3; unnamed protein product; Very long-chain acyl-CoA synthetase homolog 3; VLCS-3
基因别名: ACSVL3; FATP3; PSEC0067; SLC27A3; UNQ367/PRO703; VLCS-3
UniProt ID: (Human) Q5K4L6, (Mouse) O88561
Entrez Gene ID: (Human) 11000, (Mouse) 26568